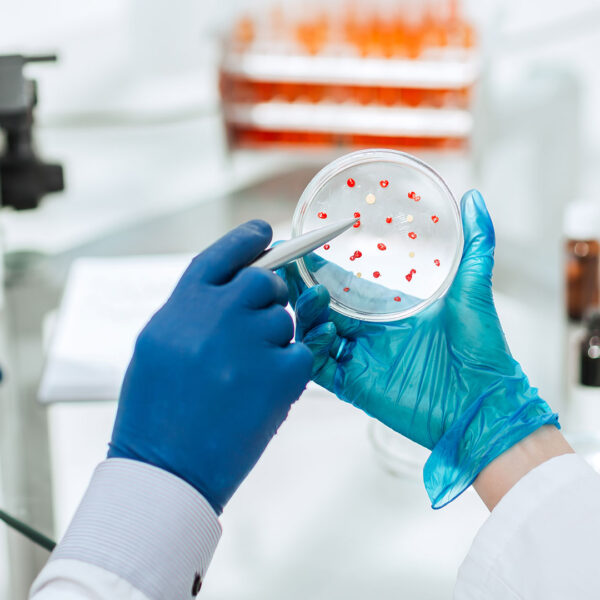

DNA

Laboratory
Biomedical

Laboratory

Microbiology

Immunology
